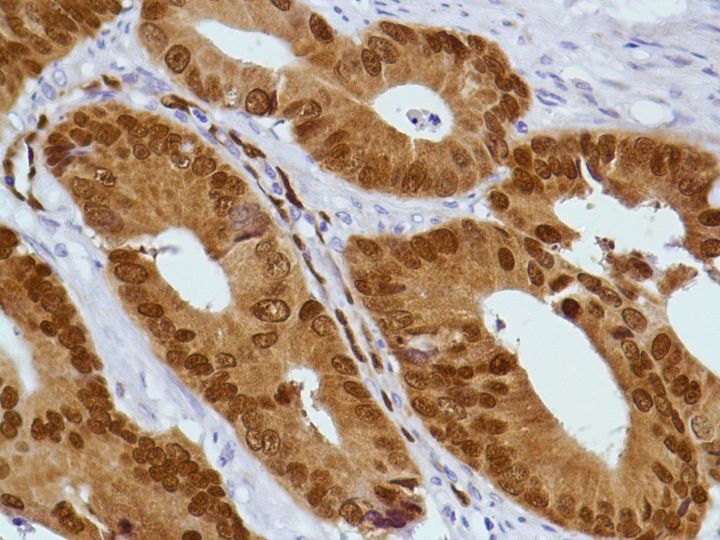

CDX2 (SP54)
CDX2 is a caudal type homeobox gene that encodes an intenstine-specific transcription factor that is expressed early in intestinal development and may be involved in the regulation of proliferation and differentiation of intestinal epithelial cells. It is expressed in the nuclei of epithelial cells throughout the intestine, from duodenum to rectum. The CDX2 protein is expressed in primary and metastatic colorectal carcinomas and has also been demonstrated in the intestinal metaplasia of the stomach and intestinal-type gastric cancer, while it is not expressed in the normal gastric mucosa. Studies have shown that CDX2 is superior marker compared in CK20.
....Related Files